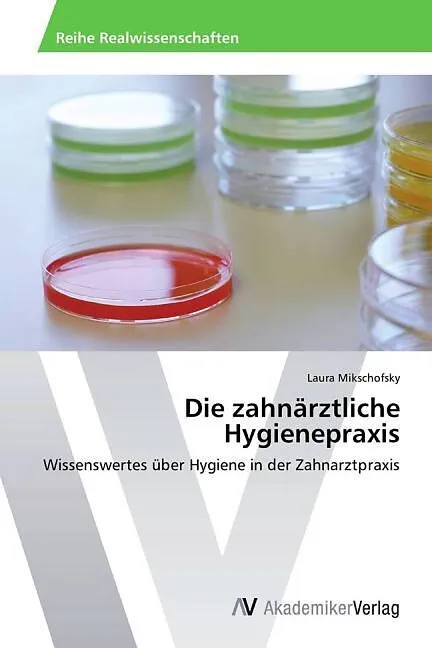
Die zahnärztliche Hygienepraxis

Die zahnärztliche Hygienepraxis
Einband:
Kartonierter Einband (Kt)
EAN:
9783639486629
Genre:
Zahnheilkunde
Autor:
Laura Mikschofsky
Herausgeber:
AV Akademikerverlag
Hygienerichtlinien, besonders in Zahnarztpraxen werden oft stiefmütterlich behandelt. Dieser Leitfaden gibt Informationen über die korrekte Handhabung und Umsetzung von Hygieneplänen in der Praxis. Besonders umfassend wird das Thema "Wasser" und Keimbelastungen in den wasserführenden Behandlungsstühlen behandelt. Weitere Bereiche sind die korrekte Desinfektion, Sterilisation und Wartung medizinisch technischer Geräte, um in der ambulanten Praxis einen hohen Hygienestandard bieten zu können.
Autorentext
Laura Mikschofsky, Jahrgang 1986. Dr. med. dent.2004-2012 Studium der Zahnmedizin an der medizinischen Universität Graz und seit 2012 als Assistenzzahnärztin in der Schweiz tätig.Initiantin und Betreuerin des Projektes für Entwicklungszusammenarbeit "Zähne für Afrika", Moshi/Tanzania (www.zaehnefuerafrika.com)
Klappentext
Hygienerichtlinien, besonders in Zahnarztpraxen werden oft stiefmütterlich behandelt. Dieser Leitfaden gibt Informationen über die korrekte Handhabung und Umsetzung von Hygieneplänen in der Praxis. Besonders umfassend wird das Thema "Wasser" und Keimbelastungen in den wasserführenden Behandlungsstühlen behandelt. Weitere Bereiche sind die korrekte Desinfektion, Sterilisation und Wartung medizinisch technischer Geräte, um in der ambulanten Praxis einen hohen Hygienestandard bieten zu können.

Leider konnten wir für diesen Artikel keine Preise ermitteln ...
billigbuch.ch sucht jetzt für Sie die besten Angebote ...
Die aktuellen Verkaufspreise von 6 Onlineshops werden in Realtime abgefragt.
Sie können das gewünschte Produkt anschliessend direkt beim Anbieter Ihrer Wahl bestellen.
Loading...
Die aktuellen Verkaufspreise von 6 Onlineshops werden in Realtime abgefragt.
Sie können das gewünschte Produkt anschliessend direkt beim Anbieter Ihrer Wahl bestellen.
| # | Onlineshop | Preis CHF | Versand CHF | Total CHF | ||
|---|---|---|---|---|---|---|
| 1 | Seller | 0.00 | 0.00 | 0.00 |